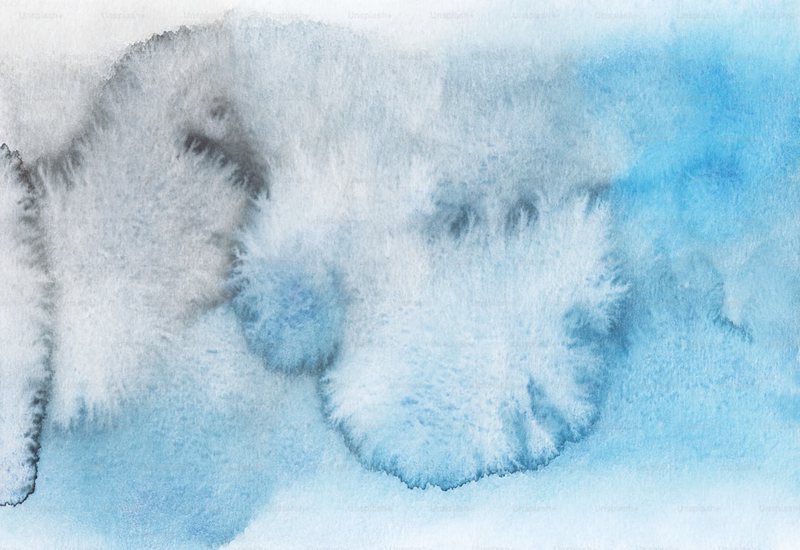
北美冰霜猫妖｜大自然的魔法画师

你有没有想过,为什么冬天的玻璃窗上会出现那些精美的“冰霜画”?它们像是被艺术家亲手绘制出来的一样,有的像树木,有的像花朵,还有的甚至像是小动物的爪印。这些奇妙的图案其实并不是什么神秘的魔法,而是大自然的鬼斧神工——霜花。今天,我们就来聊聊这种被称为“北美冰霜猫妖”的自然现象,看看它背后的科学秘密。### 什么是霜花?
霜花,就是霜在物体表面形成的漂亮图案。它们一般在寒冷的冬天出现,最常见的地方是玻璃窗、金属门,还有汽车的挡风玻璃上。霜花的形状各种各样,有的像树枝,有的像羽毛,还有的就像被风吹动的蒲公英种子一样。那么,霜花到底是怎么形成的呢?其实,这是一个简单又神奇的过程。
当空气中的水蒸气遇到温度低于零度的物体表面时,就会直接凝结成冰晶。这些冰晶会附着在物体表面,并随着时间慢慢形成各种美丽的图案。比如温度、湿度和气流不同,这些因素都会影响霜花的形状。
冰晶在物体表面相遇时,会因为表面的微小不平而形成各种各样的形状。有趣的是,霜花的形成还与物体的材质密切相关。例如,玻璃窗上的霜花通常呈现出较为规整的图案,而金属门上的霜花则可能显得更加粗糙。这主要是因为不同材质的表面微观结构不同,导致冰晶附着的方式也不同。在北美,霜花还有一个有趣的名字——“冰霜猫妖”。
这个名字听起来像是某种神秘的生物,但实际上只是人们对霜花的一种形象的称呼。传说中,“冰霜猫妖”会在寒冷的夜晚偷偷溜进人类的家中,在窗户上画出精美的图案,仿佛在展示大自然的魔法。虽然这只是个传说,但霜花的美丽确实让人感叹大自然的神奇。无论是清晨看到窗玻璃上的霜花,还是开车时看到挡风玻璃上的冰晶,这些瞬间都像是大自然在和我们打招呼,提醒我们冬天的美好。### 霜花的科学意义 霜花不仅是自然的杰作,还为我们提供了一个观察微观世界的窗口。
通过研究霜花的形状和结构,科学家们可以更好地理解水蒸气在低温下的凝结过程,甚至还能从中获得一些启发,用于材料科学和工程领域的研究。比如,科学家们发现,霜花的结构非常类似某些高效的隔热材料。通过模仿霜花的形状,他们可以设计出更轻便、更高效的隔热材料,在建筑、航空航天等领域发挥重要作用。### 结语 霜花,这个被称为“北美冰霜猫妖”的自然现象,虽然看似简单,却蕴含着丰富的科学知识和无尽的美感。下次当你看到窗户上的霜花时,不妨停下来看看,试着想象一下这些冰晶是如何在寒冷的空气中舞动,最终在玻璃上绘制出一幅幅精美的图案的。
也许,这就是大自然最浪漫的创作方式——用冰晶画笔,为世界增添一份冬日的惊喜。



